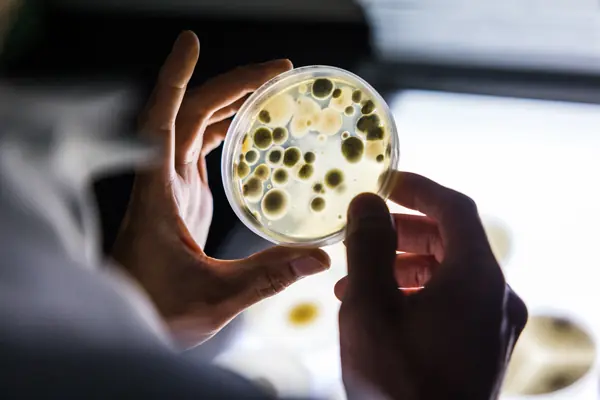

Dans un contexte où la sécurité alimentaire et la qualité des produits agroalimentaires sont au cœur des préoccupations industrielles, le rôle des microorganismes d’altération devient un enjeu stratégique majeur. Ces micro-organismes, invisibles à l’œil nu mais aux conséquences bien concrètes, sont capables de compromettre la conservation, la saveur, l’apparence et la commercialisation des aliments.
C’est dans cette optique que se tiendra, du 24 au 26 juin 2025 à Quimper, le colloque Spoilers In Food 2025, un événement scientifique international organisé par ADRIA, le LUBEM (Université de Bretagne Occidentale) et la Technopole Quimper-Cornouaille. Pendant trois jours, des chercheurs, experts internationaux, industriels et professionnels du secteur alimentaire se réuniront pour partager les dernières avancées scientifiques, explorer des solutions innovantes et échanger autour des défis liés aux micro-organismes d’altération.
Au programme : des keynotes scientifiques de haut niveau, des sessions thématiques, des posters, des échanges de bonnes pratiques et surtout, un objectif commun : mieux comprendre, détecter et maîtriser ces “spoilers” qui impactent l’intégrité des produits alimentaires.
Un rendez-vous international pour l’industrie agroalimentaire
Le colloque Spoilers In Food 2025 marque le retour d’un événement de référence dans le domaine de la microbiologie alimentaire appliquée à l’altération des aliments. Après une interruption depuis sa dernière édition en 2017, principalement liée à la pandémie, cette rencontre scientifique internationale reprend en 2025 avec une dynamique réaffirmée et la volonté de relancer les échanges entre chercheurs et industriels autour des défis posés par les micro-organismes d’altération.

Organisé par trois structures complémentaires et reconnues pour leur engagement dans l’innovation et la recherche appliquée :
- ADRIA, centre technique agroalimentaire basé en Bretagne, accompagne les entreprises sur les problématiques de qualité, sécurité microbiologique, R&D et transfert technologique.
- Le LUBEM, laboratoire universitaire rattaché à l’Université de Bretagne Occidentale, mène des travaux scientifiques de pointe sur la physiologie, la génétique et l’écologie microbienne dans les aliments.
- La Technopole Quimper-Cornouaille, moteur d’innovation sur le territoire breton, soutient le développement de filières stratégiques, en lien avec les enjeux économiques et environnementaux actuels.
Cette complémentarité garantit un programme scientifique rigoureux, structuré autour de problématiques concrètes, actuelles et profondément ancrées dans les réalités industrielles.
Le colloque s’adresse directement aux responsables qualité, directeurs R&D, ingénieurs, chefs de projet, consultants, responsables innovation, experts en sécurité alimentaire, analystes et scientifiques engagés dans la maîtrise des contaminations, la préservation des produits, et la réduction des pertes tout au long de la chaîne alimentaire.
Même si cette quatrième édition a des allures de nouveau départ, elle s’inscrit pleinement dans une dynamique internationale assumée. Les conférences se dérouleront exclusivement en anglais, et les organisateurs ambitionnent d’accueillir au moins 40 % de participants non francophones, issus d’universités, d’instituts de recherche et d’industries agroalimentaires d’Europe et d’ailleurs.
Pourquoi s’intéresser aux micro-organismes d’altération ?
Invisible, silencieuse, souvent détectée tardivement, l’altération microbienne est pourtant fréquente dans les filières agroalimentaires. Elle peut survenir à toutes les étapes de la chaîne, depuis les matières premières jusqu’au produit fini, en passant par la transformation, le conditionnement ou la distribution.
Si les micro-organismes pathogènes sont naturellement au cœur des préoccupations en matière de sécurité sanitaire, les micro-organismes d’altération représentent un enjeu majeur en termes de qualité, de gaspillage et de performance économique.
Un seul micro-organisme – qu’il s’agisse d’une levure, d’une bactérie ou d’une moisissure – peut suffire à compromettre la qualité d’un lot, avec pour conséquences possibles :
- des pertes de produits ou un gaspillage alimentaire,
- des retours ou rappels de lots,
- une dégradation de l’image de marque,
- des surcoûts liés aux ajustements de process ou à des actions correctives,
- voire, dans certains cas, une non-conformité empêchant la mise sur le marché.
Des enjeux bien réels pour les industriels
Les micro-organismes d’altération ne présentent pas de risque sanitaire direct dans la majorité des cas, mais ils peuvent rendre les produits non conformes aux attentes du marché. Apparition de gaz, gonflement d’emballage, altérations visuelles, développement de biofilms, modification du goût ou de l’odeur… autant de signes de dégradation susceptibles de survenir de manière progressive ou rapide, selon les conditions.
Dans une logique d’amélioration continue et de maîtrise qualité, la surveillance de ces flores altérantes est devenue une composante essentielle pour plusieurs filières :
- Produits laitiers : gonflement, défauts sensoriels, fermentations secondaires.
- Produits carnés et charcuteries : coloration anormale, odeurs, instabilités.
- Produits végétaux transformés : développement de levures ou moisissures, acidification.
- Plats cuisinés et traiteur : instabilités microbiologiques liées à la complexité des formulations.
- Produits conditionnés sous vide ou en atmosphère modifiée : apparition possible de spoilers anaérobies.
Ces altérations peuvent impacter la durée de vie commerciale, entraîner des non-conformités et générer des coûts liés au rebut ou à la reformulation. Leur maîtrise contribue ainsi à la stabilité des produits, à la réduction du gaspillage, et à la satisfaction durable des clients et distributeurs.
Une problématique qui évolue
Les évolutions récentes des pratiques agricoles, des conditions de transformation, des formulations alimentaires et des facteurs climatiques contribuent à modifier les écosystèmes microbiens rencontrés dans les filières agroalimentaires.
Certaines espèces, jusqu’alors peu fréquentes, sont désormais plus régulièrement identifiées dans certaines matrices. Ces changements peuvent résulter de nouvelles conditions de production, de modifications des recettes ou encore d’outils d’analyse plus performants.
Par ailleurs, certaines souches se révèlent particulièrement tolérantes aux conditions de stress environnemental ou aux procédés de stabilisation utilisés, ce qui complexifie la maîtrise de l’altération.
Dans ce contexte, les approches classiques peuvent, dans certains cas, se révéler insuffisantes pour caractériser la diversité microbienne ou anticiper certains risques d’altération. Les outils de détection et de caractérisation doivent donc continuer à évoluer pour accompagner ces dynamiques.
Le colloque Spoilers in Food 2025 permettra d’explorer ces tendances à travers des études de cas industrielles, des résultats de recherche appliquée et des techniques avancées d’identification microbienne, issues de la recherche académique.
Mieux connaître pour mieux maîtriser
Mieux connaître les micro-organismes d’altération, ce n’est pas uniquement les identifier : c’est aussi comprendre leurs métabolismes, anticiper leur développement dans un contexte donné, et ajuster les paramètres techniques pour limiter leur impact sur la qualité des produits.
Cette approche favorise également le dialogue entre recherche et industrie, en mettant en évidence des leviers d’action tels que l’ajustement des formulations, le design hygiénique des équipements, la maîtrise des procédés de nettoyage (CIP) ou encore le suivi précis de la chaîne du froid.
L’approfondissement de ces connaissances peut contribuer à une meilleure gestion des risques microbiologiques et à l’optimisation des stratégies de maîtrise, dans une logique de performance, de durabilité et de sécurité.

Une science en mouvement : nouveaux défis pour l’industrie
La compréhension des micro-organismes d’altération a fortement progressé au cours des dernières décennies. L’émergence de nouvelles technologies – biologie moléculaire, métagénomique, spectrométrie de masse, bio-informatique – a permis d’explorer avec une précision accrue la diversité microbienne présente dans les aliments et leurs environnements de production.
Ces outils ont ouvert la voie à une meilleure identification des espèces, à l’analyse des interactions microbiennes complexes, et à la caractérisation de souches jusqu’ici peu documentées.
Parallèlement, les filières agroalimentaires font face à de nouvelles contraintes : diversification des produits, exigences clean label, évolution des pratiques industrielles, adaptation aux réglementations… autant de facteurs qui rendent la gestion des risques d’altération plus complexe et nécessitent des approches plus intégrées et prédictives.
Changements climatiques et pressions environnementales
Le changement climatique peut influencer, de manière directe ou indirecte, la dynamique des écosystèmes microbiens associés à la chaîne agroalimentaire. Des facteurs comme l’augmentation des températures, l’humidité ambiante, ou encore la fréquence accrue des événements climatiques extrêmes modifient certains paramètres de production, de transport ou de conservation.
Dans ce contexte, certaines espèces jusqu’alors peu présentes peuvent devenir plus fréquemment détectées, notamment des souches thermotolérantes ou résistantes à certains stress technologiques. Ces changements peuvent affecter la composition des flores microbiennes dans certains environnements de production, notamment lorsqu’ils sont exposés à des variations non anticipées.
Cela invite les entreprises à réévaluer certains aspects de leur maîtrise microbiologique, tels que :
- les conditions de transport et de stockage,
- les stratégies de nettoyage et de désinfection,
- la conception des ateliers en lien avec la gestion thermique et hygrométrique,
- et, plus largement, l’adaptation des procédés aux conditions évolutives.
Nouveaux produits, nouveaux risques
La demande croissante pour des produits :

- moins transformés (clean label),
- pauvres en additifs,
- végétariens ou végétaliens,
- enrichis en fibres ou en protéines alternatives,
… conduit au développement de matrices alimentaires nouvelles, dont les profils microbiens peuvent différer des produits conventionnels. Selon leur composition, certaines formulations peuvent être plus sensibles à des fermentations spontanées, à une efficacité réduite des conservateurs, ou à des contaminations croisées lors de la fabrication.
Parallèlement, l’évolution vers des emballages plus durables et écoconçus s’accompagne de caractéristiques technologiques différentes. Par exemple, certaines solutions limitent l’usage de plastiques barrières ou modifient les conditions d’atmosphère interne. Ces innovations, bien que pertinentes sur le plan environnemental, nécessitent une évaluation microbiologique adaptée, en fonction du produit concerné.
Enfin, si la chaîne du froid reste un pilier central de la conservation, elle peut ne pas suffire à inhiber certains micro-organismes psychrotrophes, capables de se développer à basse température.
Ces évolutions renforcent la nécessité d’une approche globale, combinant formulation, procédés, choix des matériaux d’emballage et conditions de distribution, pour garantir la stabilité et la qualité des produits.
Vers une microbiologie prédictive ?
L’un des grands défis scientifiques actuels est de passer d’une microbiologie réactive, fondée sur l’observation a posteriori, à une microbiologie prédictive, capable d’anticiper les comportements microbiens dans différents contextes de production et de conservation.
Cela implique de :
- modéliser le développement des spoilers dans des matrices alimentaires variées,
- anticiper les effets des interactions microbiennes complexes,
- et adapter les outils de surveillance environnementale à cette dynamique évolutive.
Des outils comme Sym’Previus, développé notamment avec le soutien d’ADRIA et de partenaires scientifiques, s’inscrivent dans cette approche. Il permet de simuler la croissance de micro-organismes en fonction de plusieurs paramètres (température, pH, aw, gaz, etc.), offrant ainsi aux industriels des leviers concrets pour ajuster leurs procédés et renforcer la stabilité de leurs produits.

Le colloque Spoilers In Food 2025 abordera en profondeur ces transitions, en présentant des travaux de recherche sur :
- la modélisation mathématique du comportement des micro-organismes d’altération,
- l’impact des pratiques industrielles sur la biodiversité microbienne,
- et des stratégies intégrées de contrôle, conciliant sécurité, qualité et naturalité.
L’ambition du colloque est de transformer la science en outils opérationnels. L’échange entre laboratoires, pôles d’innovation et industriels est une condition indispensable pour mettre la microbiologie au service de la performance agroalimentaire. En participant, vous accéderez à des résultats récents, parfois encore non publiés, qui pourraient inspirer vos propres projets : nouveaux plans de contrôle, adaptation de lignes de production, ou conception de produits plus stables dans le temps.
Trois thématiques clés pour trois jours de réflexion
Le programme scientifique de Spoilers in Food 2025 s’articule autour de trois axes complémentaires, conçus pour explorer les mécanismes d’altération microbienne et les leviers de maîtrise à la disposition des professionnels de l’agroalimentaire. Chaque thématique sera développée à travers des conférences plénières, des présentations orales, des communications affichées et des temps d’échange.
1. Biodiversité microbienne et identification des spoilers
Mieux maîtriser l’altération passe d’abord par une caractérisation fine des micro-organismes impliqués. Cette première thématique portera sur la diversité des espèces rencontrées dans les filières agroalimentaires, leurs origines possibles et les outils disponibles pour les détecter.

Les intervenants aborderont notamment :
- les méthodes d’identification classiques et moléculaires,
- les approches de typage et de cartographie du microbiome,
- la détection de souches émergentes ou atypiques,
- et les stratégies pour retracer les voies de contamination.
Ces travaux permettront d’illustrer comment une meilleure connaissance de la diversité microbienne peut alimenter des démarches de gestion des risques plus ciblées et efficaces.
2. Physiologie, métabolisme et interactions dans les environnements alimentaires

Cette deuxième thématique explorera le comportement des micro-organismes dans leur environnement. Comment se développent-ils ? Quelles sont leurs capacités d’adaptation ? Comment interagissent-ils avec leur matrice, les conditions de production ou d’autres espèces microbiennes ?
Parmi les sujets abordés :
- les facteurs influençant la croissance (pH, température, activité de l’eau, etc.),
- les mécanismes de résistance environnementale,
- le rôle des biofilms dans la persistance microbienne,
- les interactions inter-espèces pouvant favoriser ou inhiber l’altération.
L’objectif est de mieux comprendre ces dynamiques pour alimenter des stratégies de maîtrise fondées sur la connaissance du vivant et adaptées aux contraintes des filières.
3. Stratégies de contrôle et leviers de prévention

Enfin, la troisième thématique proposera une synthèse des approches de maîtrise, en mettant en lumière des solutions existantes ou en développement, adaptées à différents contextes de production.
Les communications porteront sur :
- des procédés de stabilisation (thermiques, non thermiques, biotechnologiques),
- l’utilisation de cultures protectrices ou d’outils de biocontrôle,
- les apports des emballages fonctionnels ou des atmosphères modifiées,
- et les dispositifs de surveillance environnementale.
L’enjeu est de montrer comment ces solutions peuvent s’intégrer dans une démarche globale de gestion de l’altération, en tenant compte des objectifs de qualité, de durabilité et de sécurité alimentaire.
Les intervenants clés : experts internationaux et approches pionnières
Plusieurs chercheurs de renom interviendront en conférence plénière pour partager leurs travaux récents sur l’altération des aliments. Parmi les interventions confirmées :
- W. Albertin (INRAE) – 10 years of research on Brettanomyces bruxellensis, the wine spoiler
- Jeanne-Marie Membré (INRAE) – Impact of climate change on food spoilers
- M. Nierop Groot (Wageningen University) – Microbiological challenges for plant-based meat and dairy analogues
- Francesca de Filippis (University of Naples Federico II) – Mapping the microbiome in food industries to improve food quality and fight spoilage




Une cinquième keynote est en cours de confirmation et sera annoncée prochainement.
Des sessions scientifiques, mais aussi des échanges concrets
Spoilers in Food 2025 propose un programme construit pour favoriser à la fois la diffusion de résultats scientifiques et les retours d’expérience du terrain. Les contenus sont conçus pour encourager les échanges entre chercheurs et professionnels de l’industrie agroalimentaire.
Durant les trois jours du colloque, plusieurs formats complémentaires permettront aux participants de s’approprier les avancées récentes en microbiologie alimentaire :
- Conférences plénières : présentations par des experts internationaux sur les tendances émergentes et les résultats de projets de recherche récents.
- Sessions orales thématiques : communications scientifiques ciblées sur les trois axes du colloque.
- Posters scientifiques : travaux en cours ou finalisés, présentés sous format affiché pour faciliter les discussions directes avec les auteurs.
- Temps d’échange et de networking : moments dédiés aux rencontres entre chercheurs, industriels, responsables qualité et étudiants.
Au-delà des contenus académiques, l’événement se veut ouvert à la pratique : de nombreuses interventions porteront sur des contextes industriels réels, avec des exemples d’application sur le terrain, des protocoles de test, ou des méthodes de diagnostic microbiologique utilisées dans les usines.
Une interface entre science et application
Cet équilibre entre rigueur scientifique et opérationnalité fait de Spoilers in Food un colloque à forte valeur ajoutée pour les professionnels. Il offre l’opportunité:
- d’actualiser ses connaissances sur les micro-organismes d’altération,
- d’échanger avec les équipes de recherche travaillant sur des problématiques similaires,
- et de repartir avec des pistes concrètes pour renforcer ses stratégies de maîtrise microbiologique.
Le colloque contribue ainsi à créer du lien entre les avancées scientifiques et les besoins des industriels, dans une logique de progrès continu pour la qualité et la sécurité des aliments.
Un ancrage territorial stratégique
Le colloque se tiendra à Quimper, au cœur d’un territoire fortement investi dans l’innovation agroalimentaire. Ce choix s’inscrit dans la continuité du travail mené localement par les organisateurs, en lien étroit avec les acteurs économiques et académiques bretons.
La région Bretagne, et notamment le Sud-Finistère, constitue un écosystème reconnu pour sa dynamique en recherche appliquée, en transfert de compétences et en accompagnement des filières agroalimentaires.
L’événement bénéficie du soutien actif de Quimper Bretagne Occidentale (QBO), du Département du Finistère et de la Région Bretagne, engagés aux côtés des structures organisatrices pour favoriser la diffusion des connaissances et renforcer l’attractivité scientifique du territoire.



Early bird jusqu’au 31 mars : pourquoi attendre ?
Les inscriptions au colloque Spoilers in Food 2025 sont ouvertes, avec une offre tarifaire préférentielle valable jusqu’au 31 mars 2025. Cette période dite early bird permet aux participants de bénéficier d’un tarif réduit, tout en réservant leur place pour cet événement réunissant des experts de différents pays.
L’inscription comprend :
- l’accès à l’ensemble des conférences plénières et sessions scientifiques,
- la participation aux temps d’échange, aux pauses café et aux déjeuners,
- le cocktail d’accueil organisé le soir du 24 juin,
- le dîner de gala prévu le 25 juin au soir,
- les supports et actes du colloque.
Cette offre early bird constitue une opportunité de planifier votre participation dans les meilleures conditions, en combinant accès à un contenu scientifique de haut niveau et temps de convivialité propices aux échanges professionnels.
👉 Toutes les modalités pratiques, détails des tarifs et lien d’inscription sont disponibles sur le site officiel :
🔗 spoilers25.sciencesconf.org

Pour qui est ce colloque ?
Spoilers in Food 2025 s’adresse à tous les professionnels confrontés, de près ou de loin, aux questions d’altération microbienne dans les aliments et leurs environnements de production. Il réunit des profils issus de secteurs variés, mais partageant un objectif commun : mieux comprendre et mieux maîtriser les micro-organismes d’altération dans un contexte industriel exigeant.
Ce colloque s’adresse notamment à :
- Responsables qualité et sécurité des aliments, engagés dans la maîtrise microbiologique au quotidien.
- Ingénieurs R&D et innovation, intéressés par les dernières avancées en formulation, conservation, packaging ou procédés.
- Microbiologistes et experts en analyse en laboratoire industriel ou institutionnel.
- Chefs de projet, consultants ou managers techniques, en charge du suivi des risques, des plans de contrôle ou des audits internes.
- Chercheurs académiques, doctorants et post-doctorants spécialisés en microbiologie alimentaire.
- Enseignants, formateurs et acteurs du transfert de connaissances dans le domaine agroalimentaire.
Un point commun : l’intérêt pour la maîtrise de l’altération
Que vous travailliez sur des produits frais, fermentés, prêts à consommer, exportés, sous atmosphère modifiée ou sans conservateurs, les enjeux sont similaires : limiter les pertes, préserver la qualité, garantir la stabilité et protéger l’image de marque.
Le programme du colloque a été conçu pour répondre à cette diversité de besoins, en combinant :
- des résultats scientifiques transférables à l’industrie,
- des retours d’expériences concrets,
- et des espaces d’échange entre pairs.
Des retombées concrètes pour les professionnels du secteur
La participation au colloque Spoilers in Food 2025 permet d’accéder à des contenus scientifiques et techniques directement en lien avec les problématiques rencontrées dans les filières agroalimentaires. Le programme est structuré de manière à favoriser l’application des connaissances au contexte industriel.

Approfondir la compréhension des phénomènes d’altération
Les conférences et présentations permettront aux participants de :
- mieux caractériser les micro-organismes d’altération présents dans leurs filières,
- comprendre les facteurs environnementaux et technologiques influençant leur développement,
- identifier des outils ou approches complémentaires pour évaluer et surveiller leur impact sur la qualité des produits.
Actualiser les pratiques de gestion microbiologique
Certains travaux présentés s’appuient sur des cas d’étude en lien avec des environnements industriels. Ils pourront alimenter la réflexion sur :
- la conception ou la révision de plans de maîtrise microbiologique,
- l’intégration de nouveaux paramètres de suivi ou de diagnostic,
- la sélection de stratégies de contrôle adaptées à des produits spécifiques.
Favoriser les échanges techniques entre acteurs
Le format du colloque inclut des temps d’échange destinés à faciliter les interactions entre :
- chercheurs spécialisés en microbiologie alimentaire appliquée,
- professionnels impliqués dans les activités de qualité, R&D ou production,
- et acteurs du transfert technologique.
Ces échanges peuvent contribuer à mettre en perspective les pratiques existantes et à identifier des solutions expérimentées dans d’autres contextes industriels.
Un engagement fort pour la recherche appliquée
Le colloque Spoilers in Food 2025 s’inscrit dans la continuité des travaux menés par l’ADRIA et le LUBEM, deux structures fortement impliquées dans le développement de connaissances transférables à l’industrie agroalimentaire. Leur mission commune : mieux comprendre les mécanismes microbiens à l’origine de l’altération des aliments et accompagner les entreprises dans la mise en œuvre de solutions adaptées.
Une expertise de terrain appuyée par la recherche académique
- ADRIA, en tant que centre technique agroalimentaire, travaille au quotidien avec les entreprises sur des problématiques concrètes : stabilité produit, maîtrise des contaminants, hygiène des équipements, formulation, conservation…
- Le LUBEM, laboratoire universitaire rattaché à l’Université de Bretagne Occidentale, développe des recherches fondamentales et appliquées en microbiologie alimentaire : écologie microbienne, biofilms, résistance environnementale, interactions entre espèces, modélisation…
Leur collaboration est structurée au sein de l’UMT ACTIA TRANSISPORE (Transfert de connaissances et d’innovations sur les spores et micro-organismes altérants dans les filières alimentaires), un dispositif labellisé qui réunit depuis 2021 les expertises scientifiques et techniques autour d’un objectif commun : optimiser la maîtrise de l’altération microbienne dans des contextes industriels variés.
🔗 En savoir plus sur l’UMT TRANSISPORE
Un lien direct entre production de connaissances et application industrielle
Les travaux menés dans le cadre de cette UMT alimentent :
- des projets de recherche collaborative,
- des prestations d’accompagnement auprès d’entreprises,
- le développement de méthodes analytiques,
- et la diffusion de référentiels techniques.
Le colloque est donc une occasion privilégiée de restituer ces résultats à un public professionnel, de mettre en débat les approches proposées, et de favoriser leur appropriation par les acteurs du terrain.
Inscription, programme et informations pratiques
Le colloque Spoilers in Food 2025 se tiendra sur trois jours, les 24, 25 et 26 juin 2025, au Centre de Congrès Le Chapeau Rouge, situé en plein cœur de Quimper. Ce lieu, adapté aux événements scientifiques, offrira un cadre propice aux conférences, aux échanges et aux moments de convivialité.
🎥 Découvrir le lieu : Centre de Congrès Le Chapeau Rouge – vidéo de présentation
Modalités d’inscription
Les inscriptions se font en ligne via la plateforme officielle :
🔗 spoilers25.sciencesconf.org
Plusieurs tarifs sont disponibles :
- Tarif early bird (jusqu’au 31 mars 2025)
- Tarif standard
- Tarif étudiant
Les frais d’inscription incluent :
- l’accès à toutes les conférences et sessions,
- les pauses café et déjeuners,
- les actes du colloque,
- le cocktail d’accueil du mardi 24 juin au soir,
- et le dîner de gala du mercredi 25 juin.
Programme et contributions scientifiques
Le programme final sera mis en ligne prochainement. Il comprendra :
- des conférences plénières données par des intervenants internationaux,
- des sessions orales réparties selon les trois thématiques principales,
- une exposition de posters scientifiques,
- des temps d’échange et de discussion.
Les communications se dérouleront en anglais.
Les chercheurs, doctorants, et professionnels souhaitant proposer une contribution peuvent soumettre leur résumé via la plateforme dédiée.
Accès et hébergement
Situé en centre-ville, le Centre de Congrès Le Chapeau Rouge est facilement accessible à pied depuis la gare ou depuis plusieurs hôtels. Des recommandations d’hébergement seront disponibles sur le site de l’événement, ainsi que des informations pratiques pour organiser votre venue.
Suivez l’actu sur LinkedIn et ne ratez rien
En attendant le jour J, l’équipe organisatrice partage régulièrement des informations sur le programme, les intervenants, les thématiques abordées et les coulisses de l’événement. Vous pouvez suivre les actualités du colloque sur LinkedIn : 🔗 SPOILERS IN FOOD 2025 – Page LinkedIn
C’est également un bon moyen de découvrir des contenus autour de la microbiologie alimentaire, parfois surprenants ou décalés, toujours en lien avec les enjeux concrets de l’altération des aliments.
Conclusion : l’altération, un enjeu à ne pas sous-estimer
Les micro-organismes d’altération peuvent être à l’origine de pertes économiques significatives, de réclamations clients ou de non-conformités qualité, selon les filières, les matrices alimentaires et les conditions de transformation. Leur développement, souvent silencieux, peut impacter la stabilité, l’acceptabilité ou la durée de vie commerciale des produits.
Mieux les comprendre, c’est disposer de leviers plus ciblés pour renforcer la maîtrise des procédés, adapter les stratégies de formulation et de conservation, et limiter les effets indésirables sur la qualité des aliments.
Le colloque Spoilers in Food 2025 offre un cadre structuré et collaboratif pour explorer ces enjeux. Que vous soyez industriel, chercheur, consultant ou acteur du transfert de connaissances, vous y trouverez des contenus applicables aux problématiques terrain, dans une démarche rigoureuse, ouverte et fondée sur l’échange entre science et pratique.
FAQ – Vos questions, nos réponses
1. Le colloque est-il réservé aux scientifiques ?
Non, il s’adresse à tous les professionnels concernés par l’altération alimentaire : industriels, ingénieurs, responsables qualité, R&D, chercheurs, consultants, etc.
2. Les présentations seront-elles traduites ?
Non, la langue officielle du colloque est l’anglais. Il n’y aura pas de traduction simultanée.
3. Peut-on proposer une communication scientifique ?
Oui, un appel à contributions est ouvert sur la plateforme. Vous pouvez soumettre un résumé pour une communication orale ou un poster.
4. Les repas sont-ils inclus dans l’inscription ?
Oui. L’inscription inclut les déjeuners, les pauses café, le cocktail d’accueil du 24 juin et le dîner de gala du 25 juin.
5. Le colloque est-il accessible aux étudiants ?
Oui, un tarif réduit est prévu pour les étudiants. Il est possible d’assister aux conférences et d’échanger avec les intervenants.
6. Est-il possible d’assister à une seule journée ?
Non, l’inscription se fait pour l’ensemble des trois jours.
7. Où aura lieu le colloque ?
Au Centre de Congrès Le Chapeau Rouge, à Quimper.
8. Comment suivre l’événement à distance ?
Aucune diffusion en ligne n’est prévue pour cette édition. La participation se fait uniquement en présentiel.